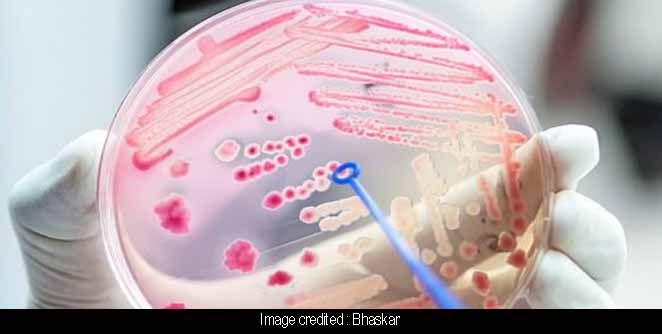

वैज्ञानिकांनी शोधला असा बॅक्टिरेया जो करतो साखरेची निर्मिती
इस्त्रायलमधील वैज्ञानिकांनी 10 वर्षांच्या रिसर्चनंतर एक असा बँक्टेरिया तयार केला आहे, जो कार्बन डायोक्साईड खाईल व साखर बनवेल. हे वातावरणाला देखील शुद्ध करण्याचे काम करेल. हा शोध व्हेइजमॅन इंस्टिट्यूट ऑफ सायन्सने लावला आहे. हे रिसर्च सेंट्रल तेल अवीव, इस्त्रायलमध्ये आहे.
जर्नल सेलमध्ये प्रकाशित रिपोर्टनुसार, ई-कॉली बँक्टेरियाला जवळपास एक दशकाच्या दीर्घ रिसर्चनंतर साखरेमधून पुर्णपणे काढण्यात आले आहे. हे काढल्यानंतर वैज्ञानिक री-प्रोग्रामिंग करण्यात यशस्वी झाले. या बॅक्टेरिया साखर खाल्यावर कार्बन डायोक्साईडचे निर्माण करायच्या, मात्र आता त्यांचे री-प्रोग्रामिंक केल्यानंतर त्या कार्बन डायोक्साईड कंज्यूम करत साखरचे निर्माण करतात. बॅक्टेरिया आपल्या बॉडीची निर्मिती पर्यावरणातील कार्बन डायोक्साईडपासून करतील व नंतर साखर निर्माण करेल.
रिसर्च सेंटरच्या वैज्ञानिंकानी दावा केला आहे की, बॅक्टेरिया हवेतील कार्बनद्वारे शरीराच्या संपुर्ण बायोमासचे निर्माण करतात. त्यामुळे आशा आहे की, या बॅक्टेरियांच्या मदतीने वातावरणातील ग्रीन हाउसचे प्रमाण कमी करण्याचे तंत्र विकसित करण्यास मदत होईल. यामुळे ग्लोबल वॉर्मिंगचा धोका देखील कमी होईल.
